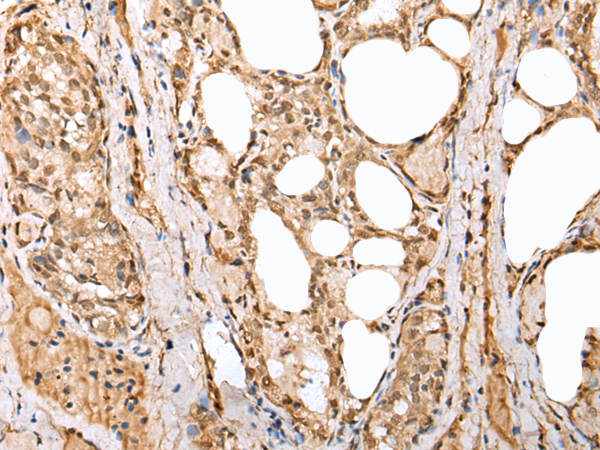
一抗

中文名稱: 兔抗PHTF2多克隆抗體
英文名稱: Anti-PHTF2 rabbit polyclonal antibody
相關(guān)類別: 一抗
儲 存: 冷凍(-20℃)
宿 主: Rabbit
抗 原: PHTF2
反應(yīng)種屬: Human, Mouse
標(biāo) 記 物: Unconjugate
克隆類型: rabbit polyclonal
技術(shù)規(guī)格
|
Background: |
PHTF2 (putative homeodomain transcription factor 2) is a 785 amino acid protein that contains one basic helix-loop-helix (bHLH) domain and belongs to the PHTF family. Homologous to PHTF1, PHTF2 exhibits strongest similarity within putative homeodomains and both N- and C-terminal regions. Existing as four alternatively spliced isoforms, PHTF2 localizes to nucleus and participates in DNA binding. PHTF2 may also play a role in transcriptional regulation. While PHTF1 is expressed mainly in testis, PHTF2 is predominantly expressed in muscle, which suggests that both may have acquired different functions after their duplication and divergence. The gene that encodes PHTF2 maps to human chromosome 7q11.23. |
|
Applications: |
ELISA, IHC |
|
Name of antibody: |
PHTF2 |
|
Immunogen: |
Fusion protein of human PHTF2 |
|
Full name: |
putative homeodomain transcription factor 2 |
|
SwissProt: |
Q8N3S3 |
|
ELISA Recommended dilution: |
2000-5000 |
|
IHC positive control: |
Human thyroid cancer and human lung cancer |
|
IHC Recommend dilution: |
25-100 |


 購物車
購物車 幫助
幫助
 021-54845833/15800441009
021-54845833/15800441009